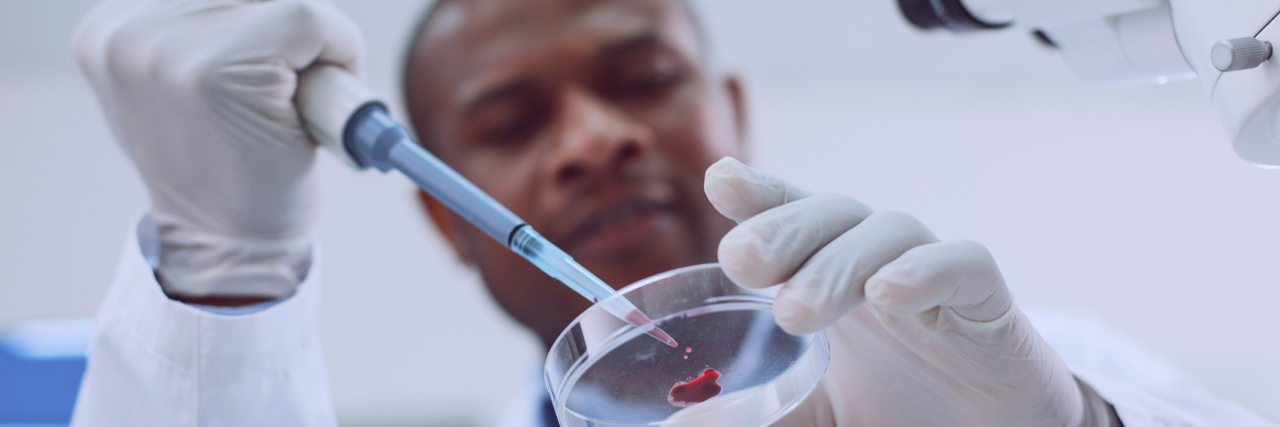
New Ohio State Research May Lead to a Reliable Fibromyalgia Blood Test Delighted skilled scientist conducting a blood test and wearing a uniform

New research from Ohio State University’s College of Medicine has potentially found a new way to detect fibromyalgia with a blood test. While they are optimistic, the study’s authors caution that more work is needed before a blood test based on their work can be created.
- What is Fibromyalgia?
- What Are Common Fibromyalgia Symptoms?
Researchers, led by rheumatologist Kevin Hackshaw, MD, published the results of their work in the Journal of Biological Chemistry. The study examined 50 people with fibromyalgia, 29 with rheumatoid arthritis, 19 with osteoarthritis and 23 with lupus.
By looking for a “metabolic fingerprint” or specific patterns of molecules in the blood of fibromyalgia patients using vibrational spectroscopy, Hackshaw and his colleagues were able to distinguish between fibromyalgia and the other conditions in their sample. He also noted the test’s potential to determine the severity of your fibromyalgia.
“These initial results are remarkable,” said study co-author Luis Rodriguez-Saona, Ph.D., in a press release. “If we can help speed diagnosis for these patients, their treatment will be better and they’ll likely have better outlooks. There’s nothing worse than being in a gray area where you don’t know what disease you have.”
Fibromyalgia can cause chronic pain all over your body, fatigue and sleep issues and thinking or memory problems like “brain fog.” Historically many doctors have dismissed the condition and told patients it’s “all in their head.” Hackshaw hopes research that could lead to a tangible test to diagnose fibromyalgia may help patients get a better diagnosis faster.
Rodriguez-Saona said the next step is to replicate the results in a larger and more diverse sample size to determine the validity of their initial work and zero in on what exactly makes the blood of people with fibromyalgia different. He and Hackshaw hope to develop a blood test from the research within five years.
While there are two blood tests that claim to diagnosis fibromyalgia already on the market — FM/a blood test and IsolateFibromyalgia — both are based on research funded solely for the purpose of creating a test by commercial companies that have yet to be replicated by a completely impartial third party. Authors of this new research caution more work is needed before a reliable blood test can be created.
“We can look back into some of these fingerprints and potentially identify some of the chemicals associated with the differences we are seeing,” Rodriguez-Saona said in a press release. This would include narrowing down exactly which proteins or acids, for example, distinguish the patterns found in the blood of those with fibromyalgia.
Hackshaw and Rodriguez-Saona hope their work leads to a better diagnostic test for fibromyalgia and therefore better treatment options. They remain optimistic about the outcome of their study.
“Most physicians nowadays don’t question whether fibromyalgia is real, but there are still skeptics out there,” Hackshaw said. “We found clear, reproducible metabolic patterns in the blood of dozens of patients with fibromyalgia. This brings us much closer to a blood test than we have ever been.”
MORE ABOUT FIBROMYALGIA:
Fibromyalgia, a chronic illness with three main symptoms — widespread pain, chronic fatigue and cognitive trouble. Fibromyalgia is a complicated illness that’s not well understood. In the past, it was mischaracterized as a mental health disorder. Even today, some doctors wave off fibro symptoms as being “all in your head.” This isn’t the case. Read The Mighty’s comprehensive guide to fibromyalgia here. Click here to join our fibro community and connect with people who get it.
Header image via Zinkevych/Getty Images.